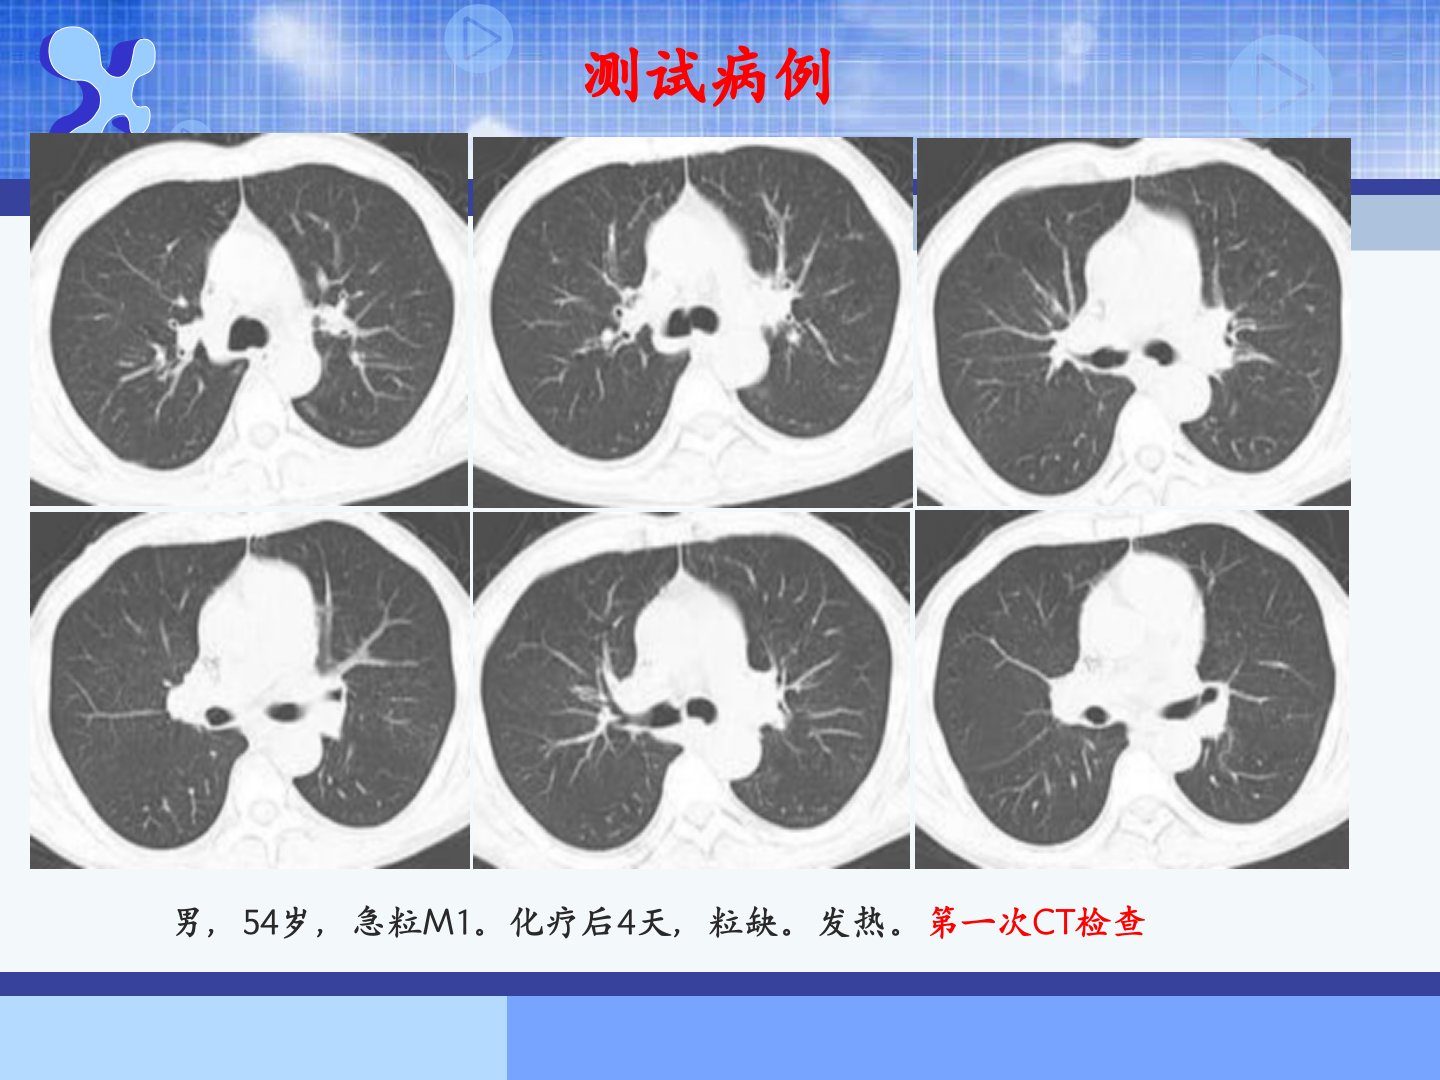

肺部曲霉菌感染的CT诊断【103页】
2025-11-15
999+
8.05MB
103 页
海报
侵权投诉

摘要:
展开>>
收起<<
54岁男性急性粒细胞白血病M1型患者化疗后粒缺发热经抗炎抗病毒治疗无效。CT复查结合纤支镜病理确诊为侵袭性支气管曲菌病。曲霉菌病是真菌感染中最常见的一种急性白血病患者发病率高误诊病死率高常见于免疫力低下、长期使用广谱抗生素等人群。诊断标准包括宿主因素、临床特征、病原菌检测等。肺曲菌病根据宿主免疫反应分为寄生性、过敏性、半侵袭性、侵袭性4种类型。侵袭性曲菌病是最常见的机遇性肺部真菌感染影像表现为早期胸膜下密度增高结节实变影后出现晕轮征1015天后出现空洞或新月征。血管侵袭性曲菌病表现为伴有晕征的小结节影抗真菌治疗后空洞形成“空气半月征”;气道侵袭性曲菌病占侵袭性肺曲菌病的1030病理为小气道壁液化坏死及中性粒细胞浸润分为气管支气管炎型、细支气管炎型、支气管肺炎型。肺部曲菌病类型与机体免疫状态有关CT表现有差异典型表现者可准确诊断不典型者需结合临床或病理确诊。
相关推荐
-
ESD患者的护理【13页】

 2025-11-02 999+
2025-11-02 999+ -
ERCP治疗胆总管结石的护理【63页】

 2025-11-02 999+
2025-11-02 999+ -
ERCP治疗胆总管结石的护理【38页】

 2025-11-02 999+
2025-11-02 999+ -
ERCP术后护理【20页】

 2025-11-02 999+
2025-11-02 999+ -
ERCP术后鼻胆管引流的护理 ppt课件【16页】

 2025-11-02 999+
2025-11-02 999+ -
ERCP的护理PPT课件【24页】

 2025-11-02 999+
2025-11-02 999+ -
ERAS(护理)-医学精品【40页】

 2025-11-02 999+
2025-11-02 999+ -
ECMO的护理(胡应炉)【36页】

 2025-11-02 999+
2025-11-02 999+ -
DSA术前及术后护理【35页】

 2025-11-02 999+
2025-11-02 999+ -
2022术后肺栓塞病人的护理ppt【32页】

 2025-11-02 999+
2025-11-02 999+



